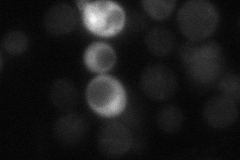
YKL159C

View description
Protein involved in calcineurin regulation during calcium signaling; has similarity to H. sapiens DSCR1 which is found in the Down Syndrome candidate region
Localization:
Intensity:
Fold change:
Significance:
-
C’ GFP library in SD

below threshold19.56 -
N' NOP1pr-GFP in SD

cytosol85.3458 -
N' TEF2pr-mCherry in SD

cytosol77.955 -
N' NATIVEpr-GFP in SD
cytosol29.2157 -
N' TEF2pr-VC and Cyto-VN in SD

cytosol32.1289 -
C’ GFP library in SD+DTT

cytosol43.052.19No -
C’ GFP library in SD+H2O2

cytosol15.650.79No -
C’ GFP library in Starvation Media

cytosol28.31.44No -
C’ GFP library on the background of Pup2-DaMP

below threshold -
C’ GFP library on the background of CCT mutant

below threshold21.89821.11881No
